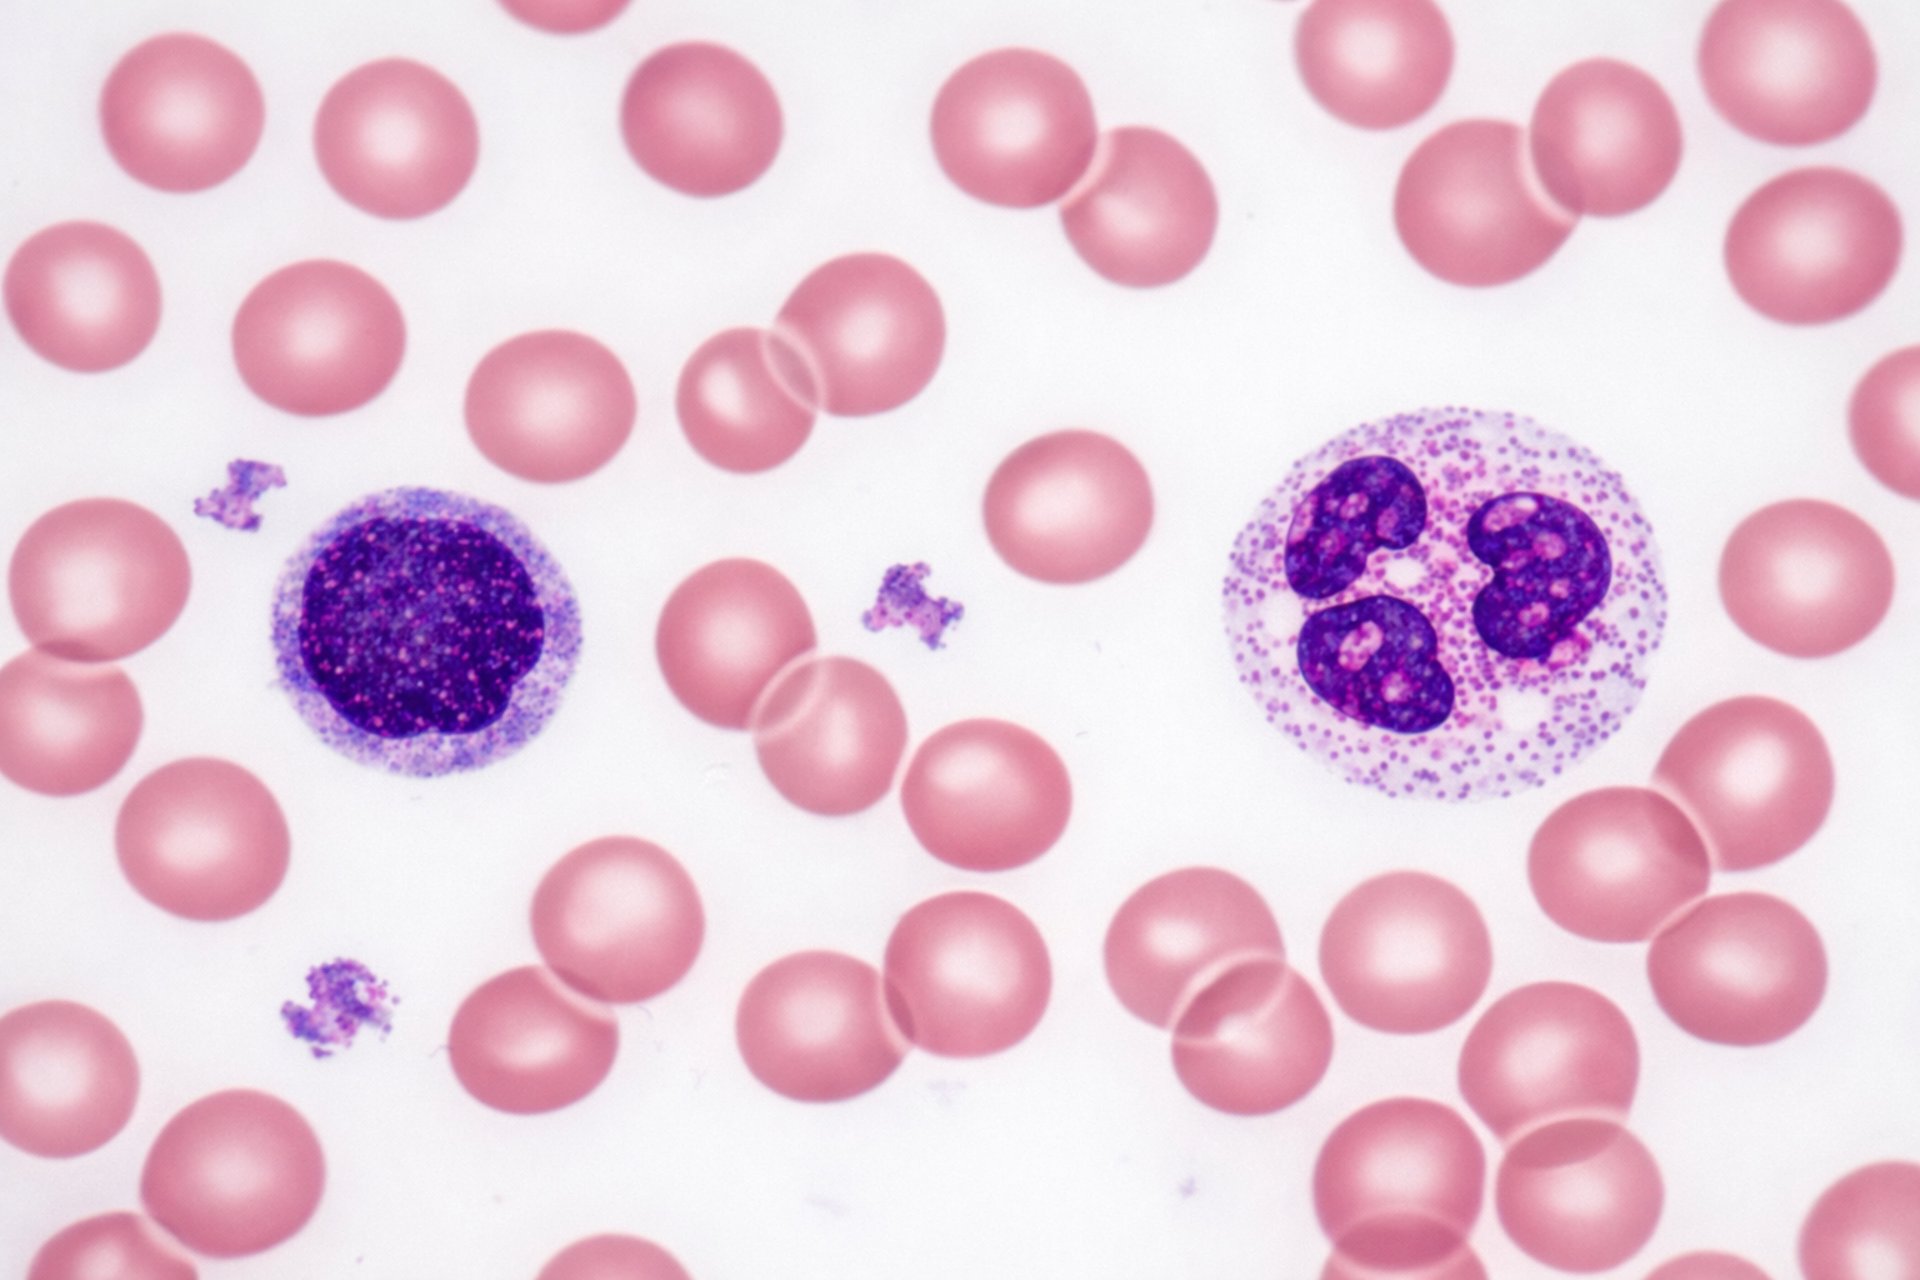

Alteração no hemograma: quando é realmente necessário procurar um hematologista?
Entenda quando alterações no hemograma exigem avaliação especializada com hematologista.
Dra Danielle Duarte
2/19/20263 min read
Hemograma
O hemograma completo (Complete Blood Count – CBC) é um dos exames laboratoriais mais solicitados na prática médica. Ele fornece informações essenciais sobre as células do sangue e frequentemente representa o primeiro sinal de que algo pode estar fora do esperado.
Entretanto, como discutido no artigo “The Complete Blood Count—Time to Assess What Is Impactful and What Is Distracting”, publicado na revista Blood, nem toda alteração identificada no hemograma possui relevância clínica imediata. Parte das variações pode ser transitória ou fisiológica.
A questão central não é apenas identificar se há alteração, mas determinar: essa alteração é clinicamente significativa?
O que o hemograma avalia ?
O hemograma analisa três grandes linhagens celulares:
Série Vermelha (Eritrograma):
A anemia deve ser interpretada considerando não apenas o valor absoluto da hemoglobina, mas também o contexto clínico, a velocidade de instalação e os sintomas associados.
Nem toda anemia leve exige investigação extensa. Entretanto, anemia persistente, progressiva ou associada a sintomas como fadiga intensa, dispneia ou palidez deve ser avaliada de forma sistemática.
Série Branca (Leucograma):
Oscilações discretas podem ocorrer em situações como infecções virais, estresse fisiológico ou uso de determinadas medicações.
São considerados achados potencialmente relevantes:
Leucocitose persistente sem causa infecciosa evidente
Linfocitose sustentada em exames seriados
Neutropenia significativa (<1.000/mm³)
Presença de células imaturas ou blastos
Plaquetas:
Alterações leves isoladas frequentemente são reacionais.
Merecem investigação especializada:
Plaquetas abaixo de 100.000/mm³
Plaquetas persistentemente acima de 450.000/mm³
Associação com sangramentos espontâneos ou eventos trombóticos
A literatura hematológica moderna propõe uma reflexão importante: devemos priorizar aquilo que realmente altera conduta clínica (impactful) e evitar supervalorizar achados isolados sem repercussão clínica (distracting).
Alterações potencialmente transitórias
Variações discretas isoladas
Valores limítrofes sem sintomas
Oscilações temporárias
Alterações que exigem atenção
Persistência ou progressão da alteração
Comprometimento de mais de uma linhagem celular
Associação com sintomas sistêmicos (febre prolongada, perda de peso, sudorese noturna)
Alterações morfológicas no esfregaço sanguíneo
A diferenciação entre esses cenários exige avaliação clínica integrada.
Quando procurar um hematologista?
A avaliação especializada é recomendada quando houver:
Persistência da alteração em exames seriados
Associação com sintomas clínicos relevantes
Citopenias múltiplas
Suspeita de doença da medula óssea
Dúvida diagnóstica após investigação inicial
A interpretação adequada permite evitar tanto exames desnecessários quanto atrasos diagnósticos.
Atenção aos seguintes sinais clínicos:
SINAIS DE ALERTA
Alterações no hemograma associadas a manifestações sistêmicas podem indicar necessidade de investigação especializada:
• Astenia significativa
• Sintomas constitucionais (febre, sudorese noturna, perda ponderal)
• Citopenias múltiplas
• Linfadenopatia persistente
• Sangramentos inexplicados
A presença desses achados justifica avaliação hematológica.
ALTERAÇÕES QUE GERALMENTE NAO INDICAM GRAVIDADE IMEDIATA
Nem toda variação laboratorial representa doença hematológica.
Alterações leves e isoladas podem estar associadas a:
• Resposta inflamatória aguda
• Variações fisiológicas individuais
• Uso de medicamentos
• Condições clínicas intercorrentes
Na ausência de sintomas ou progressão, a conduta pode ser apenas acompanhamento clínico e repetição seriada do exame.
Conclusão:
O hemograma é uma ferramenta diagnóstica de grande valor clínico. No entanto, sua interpretação exige integração entre exame físico, história clínica e análise laboratorial especializada.
Receber um exame alterado não significa automaticamente uma condição grave. Entretanto, alterações persistentes ou associadas a sintomas devem ser avaliadas com atenção.
A avaliação hematológica especializada permite um diagnóstico preciso, direcionamento adequado e acompanhamento seguro.
Avaliação especializada
Se você recebeu um hemograma com alterações ou apresenta sintomas como fadiga persistente, infecções recorrentes, sangramentos ou aumento de linfonodos, a avaliação por especialista em Hematologia pode trazer clareza diagnóstica e direcionamento seguro.
A interpretação individualizada, baseada em evidência científica atual e análise clínica integrada, é fundamental para decisões precisas.
Agende uma avaliação hematológica para análise detalhada do seu caso.
Referências Bibliográficas
The Complete Blood Count—Time to Assess What Is Impactful and What Is Distracting. Blood. American Society of Hematology.
Tefferi A. Anemia in adults: a contemporary approach to diagnosis. N Engl J Med.
Bain BJ. Diagnosis from the blood smear. N Engl J Med.
Provan D, et al. How I treat immune thrombocytopenia. Blood.
Dale DC. How I manage neutropenia. Blood.
Dra. Danielle Duarte Souza
Médica Hematologista
CRM 142588 | RQE 111021
Atendimento especializado em doenças do sangue, investigação de alterações no hemograma e acompanhamento hematológico individualizado.
